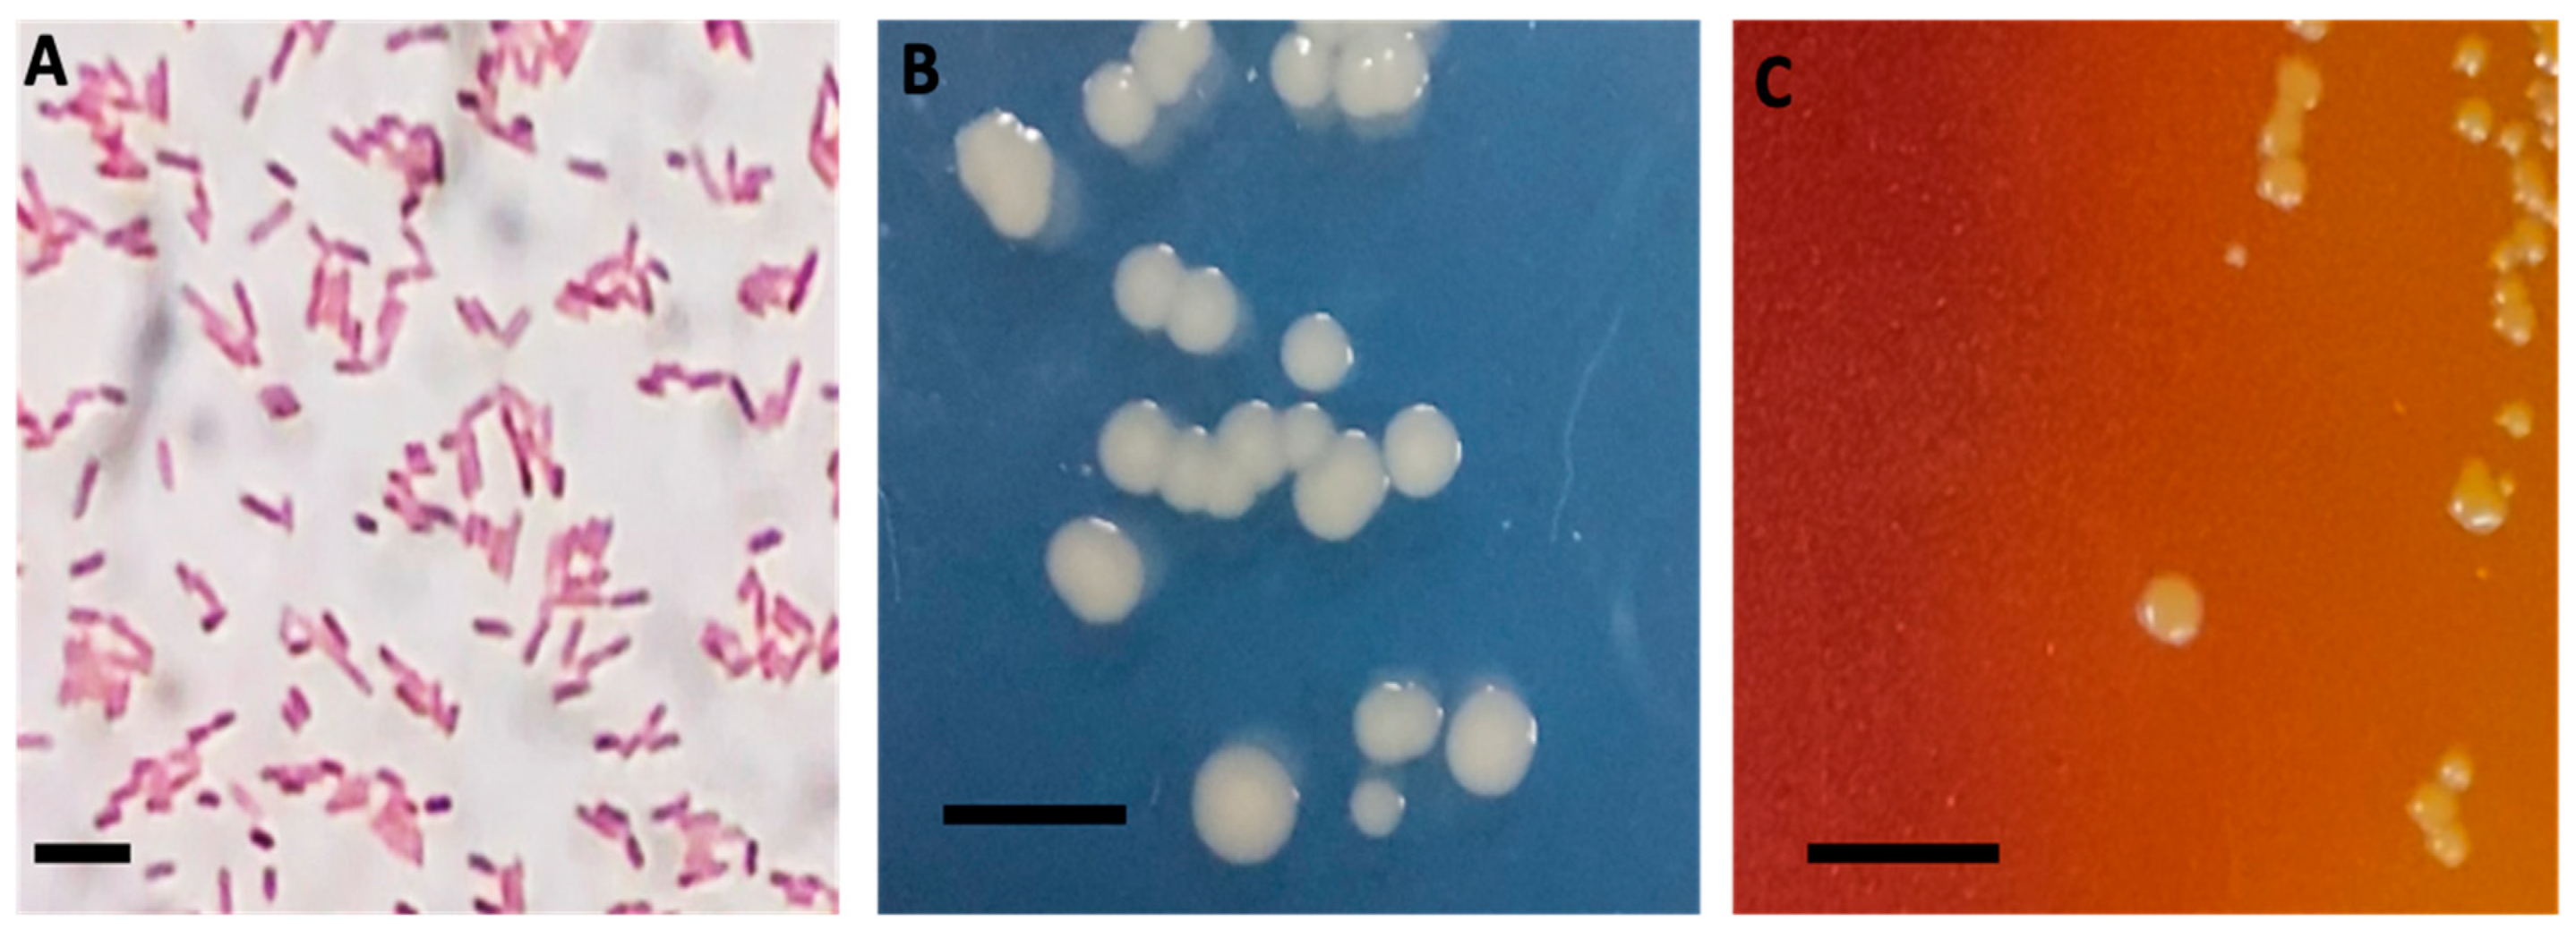
Aquacj 04 00012 g001

Pathogenicity of Aeromonas veronii from Nile Tilapia (Oreochromis niloticus) and Efficacy of Fish Oral Vaccine against Motile Aeromonad Septicemia in Tank Trials
Abstract
1. Introduction
2. Materials and Methods
2.1. Bacterial Isolation, Characterization, and Identification
2.1.1. Isolation
2.1.2. Characterization Using API and Biolog
2.1.3. Molecular Identification (16S rRNA Gene)
2.1.4. MALDI-TOF MS Identification
2.2. LD50 Bacterial Challenge Experiment
2.3. Oral Vaccine Preparation, Vaccination and Challenge Experiment
2.4. IgM Determination by Enzyme-Linked Immunosorbent Assay (ELISA)
2.5. IgM Gene Expression Analysis by RT-PCR
2.6. Statistical Analyses
3. Results
3.1. Isolation and Biochemical Characterization/Identification
3.2. Molecular and MALDI-TOF Identification of the Aeromonas DFR01 Isolate
3.3. Experimental Infection
3.4. Efficacy of Vaccine
3.5. Antibody Response by ELISA and Real Time PCR
4. Discussion
5. Conclusions
Supplementary Materials
Author Contributions
Funding
Institutional Review Board Statement
Informed Consent Statement
Data Availability Statement
Acknowledgments
Conflicts of Interest
References
- Monir, W.; Abdel-Rahman, M.A.; El-Din Hassan, S.; Mansour, E.S.; Awad, S.M.M. Pomegranate Peel and Moringa-Based Diets Enhanced Biochemical and Immune Parameters of Nile Tilapia against Bacterial Infection by Aeromonas Hydrophila. Microb. Pathog. 2020, 145, 104202. [Google Scholar] [CrossRef] [PubMed]
- Dong, H.T.; Techatanakitarnan, C.; Jindakittikul, P.; Thaiprayoon, A.; Taengphu, S.; Charoensapsri, W.; Khunrae, P.; Rattanarojpong, T.; Senapin, S. Aeromonas jandaei and Aeromonas veronii Caused Disease and Mortality in Nile Tilapia, Oreochromis niloticus (L.). J. Fish. Dis. 2017, 40, 1395–1403. [Google Scholar] [CrossRef] [PubMed]
- Li, Y.; Cai, S.-H. Identification and Pathogenicity of Aeromonas Sobria on Tail-Rot Disease in Juvenile Tilapia Oreochromis Niloticus. Curr. Microbiol. 2011, 62, 623–627. [Google Scholar] [CrossRef]
- Soto-Rodriguez, S.A.; Lozano-Olvera, R.; Garcia-Gasca, M.T.; Abad-Rosales, S.M.; Gomez-Gil, B.; Ayala-Arellano, J. Virulence of the Fish Pathogen Aeromonas dhakensis: Genes Involved, Characterization and Histopathology of Experimentally Infected Hybrid Tilapia. Dis. Aquat. Organ. 2018, 129, 107–116. [Google Scholar] [CrossRef]
- Larsen, J.L.; Jensen, N.J. An Aeromonas Species Implicated in Ulcer-Disease of the Cod (Gadus morhua). Nord. Vet. Med. 1977, 29, 199–211. [Google Scholar]
- Daily, O.P.; Joseph, S.W.; Coolbaugh, J.C.; Walker, R.I.; Merrell, B.R.; Rollins, D.M.; Seidler, R.J.; Colwell, R.R.; Lissner, C.R. Association of Aeromonas sobria with Human Infection. J. Clin. Microbiol. 1981, 13, 769–777. [Google Scholar] [CrossRef]
- Janda, J.M.; Abbott, S.L. The Genus Aeromonas: Taxonomy, Pathogenicity, and Infection. Clin. Microbiol. Rev. 2010, 23, 35–73. [Google Scholar] [CrossRef] [PubMed]
- Pessoa, R.B.G.; de Oliveira, W.F.; Correia, M.T.D.S.; Fontes, A.; Coelho, L.C.B.B. Aeromonas and Human Health Disorders: Clinical Approaches. Front. Microbiol. 2022, 13, 868890. [Google Scholar] [CrossRef]
- Yambot, A.V. Isolation of Aeromonas hydrophila from Oreochromis niloticus During Fish Disease Outbreaks in the Philippines. Asian Fish. Sci. 1998, 10, 347–354. [Google Scholar] [CrossRef]
- Pakingking, R.; Palma, P.; Usero, R. Quantitative and Qualitative Analyses of the Bacterial Microbiota of Tilapia (Oreochromis niloticus) Cultured in Earthen Ponds in the Philippines. World J. Microbiol. Biotechnol. 2015, 31, 265–275. [Google Scholar] [CrossRef]
- Legario, F.S.; Choresca, C.H., Jr.; Grace, K.; Turnbull, J.F.; Crumlish, M. Identification and characterization of motile Aeromonas spp. isolated from farmed Nile tilapia (Oreochromis niloticus) in the Philippines. J. Appl. Microbiol. 2023, 134, 12:lxad279. [Google Scholar] [CrossRef] [PubMed]
- Haenen, O.L.M.; Dong, H.T.; Hoai, T.D.; Crumlish, M.; Karunasagar, I.; Barkham, T.; Chen, S.L.; Zadoks, R.; Kiermeier, A.; Wang, B.; et al. Bacterial Diseases of Tilapia, Their Zoonotic Potential and Risk of Antimicrobial Resistance. Rev. Aquac. 2023, 15, 154–185. [Google Scholar] [CrossRef]
- Lio-Po, G.D.; Pascual, J.P.; Santos, J.G. Fish Quarantine and Fish Diseases in South East Asia; International Development Research Centre: Ottawa, ON, Canada, 1983; pp. 35–46. Available online: https://digitallibrary.un.org/record/53612?ln=es (accessed on 5 August 2024).
- Dubey, S.; Ager-Wick, E.; Kumar, J.; Karunasagar, I.; Karunasagar, I.; Peng, B.; Evensen, Ø.; Sørum, H.; Munang’andu, H.M. Aeromonas Species Isolated from Aquatic Organisms, Insects, Chicken, and Humans in India Show Similar Antimicrobial Resistance Profiles. Front. Microbiol. 2022, 13, 1008870. [Google Scholar] [CrossRef] [PubMed]
- Kayansamruaj, P.; Areechon, N.; Unajak, S. Development of Fish Vaccine in Southeast Asia: A Challenge for the Sustainability of SE Asia Aquaculture. Fish. Shellfish. Immunol. 2020, 103, 73–87. [Google Scholar] [CrossRef] [PubMed]
- Mutoloki, S.; Munang’andu, H.M.; Evensen, Ø. Oral Vaccination of Fish—Antigen Preparations, Uptake, and Immune Induction. Front. Immunol. 2015, 6, 519. [Google Scholar] [CrossRef] [PubMed]
- Leal, C.A.G.; Carvalho-Castro, G.A.; Sacchetin, P.S.C.; Lopes, C.O.; Moraes, A.M.; Figueiredo, H.C.P. Oral and Parenteral Vaccines against Flavobacterium columnare: Evaluation of Humoral Immune Response by ELISA and in Vivo Efficiency in Nile Tilapia (Oreochromis Niloticus). Aquacult. Int. 2010, 18, 657–666. [Google Scholar] [CrossRef]
- Embregts, C.W.E.; Forlenza, M. Oral Vaccination of Fish: Lessons from Humans and Veterinary Species. Dev. Comp. Immunol. 2016, 64, 118–137. [Google Scholar] [CrossRef]
- Azad, S.; Shankar, K.M.; Mohan, C.; Kalita, B. Protective Response of Common Carp Orally Vaccinated with Biofilm and Free Cells of Aeromonas hydrophila Challenged by Injection and Immersion Routes. J. Aquac. 2000, 15, 65–70. [Google Scholar]
- Vervarcke, S.; Ollevier, F.; Kinget, R.; Michoel, A. Oral Vaccination of African Catfish with Vibrio anguillarum O2: Effect on Antigen Uptake and Immune Response by Absorption Enhancers in Lag Time Coated Pellets. Fish. Shellfish. Immunol. 2004, 16, 407–414. [Google Scholar] [CrossRef]
- Palm, R.C.; Landolt, M.L.; Busch, R.A. Route of Vaccine Administration: Effects on the Specific Humoral Response in Rainbow Trout Oncorhynchus mykiss. Dis. Aquat. Org. 1998, 33, 157–166. [Google Scholar] [CrossRef]
- Esteve-Gassent, M.D.; Barrera, R.; Amaro, C. Vaccination of Market-Size Eels against Vibriosis Due to Vibrio vulnificus serovar E. Aquaculture 2004, 241, 9–19. [Google Scholar] [CrossRef]
- Akhlaghi, M. Immunogenicity of Aeromonas hydrophila in Common Carp (Cyprinus carpio, L.). J. Vet. Med. Tehran 2000, 55, 55–62. [Google Scholar]
- Rodrigues, A.P.; Hirsch, D.; Figueiredo, H.C.P.; Logato, P.V.R.; Moraes, A.M. Production and characterisation of alginate microparticles incorporating Aeromonas hydrophila designed for fish oral vaccination. Process Biochem. 2006, 41, 638–643. [Google Scholar] [CrossRef]
- Adams, A. Progress, Challenges and Opportunities in Fish Vaccine Development. Fish. Shellfish. Immunol. 2019, 90, 210–214. [Google Scholar] [CrossRef] [PubMed]
- Harshitha, M.; Nayak, A.; Disha, S.; Akshath, U.S.; Dubey, S.; Munang’andu, H.M.; Chakraborty, A.; Karunasagar, I.; Maiti, B. Nanovaccines to Combat Aeromonas hydrophila Infections in Warm-Water Aquaculture: Opportunities and Challenges. Vaccines 2023, 11, 1555. [Google Scholar] [CrossRef] [PubMed]
- Sinyakov, M.S.; Dror, M.; Lublin-Tennenbaum, T.; Salzberg, S.; Margel, S.; Avtalion, R.R. Nano- and Microparticles as Adjuvants in Vaccine Design: Success and Failure Is Related to Host Natural Antibodies. Vaccine 2006, 24, 6534–6541. [Google Scholar] [CrossRef]
- Carretero, M.I. Clay Minerals and Their Beneficial Effects upon Human Health. A Review. Appl. Clay Sci. 2002, 21, 155–163. [Google Scholar] [CrossRef]
- Palumbo, S.A.; Maxino, F.; Williams, A.C.; Buchanan, R.L.; Thayer, D.W. Starch-Ampicillin Agar for the Quantitative Detection of Aeromonas hydrophila. Appl. Environ. Microbiol. 1985, 50, 1027–1030. [Google Scholar] [CrossRef]
- Murray, R.; Doetsch, R.; Robinow, C. Determinative and Cytological Light Microscopy; American Society for Microbiology: Washington, DC, USA, 1994. [Google Scholar]
- Collins, C.H.; Lyne, P.M. Microbilogical Methods, 4th ed.; Butterworths: London, UK, 1976. [Google Scholar]
- Larkin, M.A.; Blackshields, G.; Brown, N.P.; Chenna, R.; McGettigan, P.A.; McWilliam, H.; Valentin, F.; Wallace, I.M.; Wilm, A.; Lopez, R.; et al. Clustal W and Clustal X Version 2.0. Bioinformatics 2007, 23, 2947–2948. [Google Scholar] [CrossRef]
- Camacho, C.; Coulouris, G.; Avagyan, V.; Ma, N.; Papadopoulos, J.; Bealer, K.; Madden, T.L. BLAST+: Architecture and Applications. BMC Bioinform. 2009, 10, 421. [Google Scholar] [CrossRef]
- Kumar, S.; Stecher, G.; Li, M.; Knyaz, C.; Tamura, K. MEGA X: Molecular Evolutionary Genetics Analysis across Computing Platforms. Mol. Biol. Evol. 2018, 35, 1547–1549. [Google Scholar] [CrossRef] [PubMed]
- Darriba, D.; Taboada, G.L.; Doallo, R.; Posada, D. jModelTest 2: More Models, New Heuristics and Parallel Computing. Nat. Methods 2012, 9, 772. [Google Scholar] [CrossRef]
- Ronquist, F.; Teslenko, M.; van der Mark, P.; Ayres, D.L.; Darling, A.; Höhna, S.; Larget, B.; Liu, L.; Suchard, M.A.; Huelsenbeck, J.P. MrBayes 3.2: Efficient Bayesian Phylogenetic Inference and Model Choice Across a Large Model Space. Syst. Biol. 2012, 61, 539–542. [Google Scholar] [CrossRef] [PubMed]
- Argayosa, A.M.; Pascua, C.S.; Sumera, F.; Yason, J.A.D.L.; Espigar, A.R. Oral Vaccine. Available online: https://onlineservices.ipophil.gov.ph/patgazette/IPASJournal/V18N25_INV_1st.pdf (accessed on 6 February 2024).
- Amend, D. Potency Testing of Fish Vaccines.International Symposium in Fish Biologics:Serodiagnostics and Vaccines. Dev. Biol. Stand. 1981, 49, 447–454. [Google Scholar]
- Harms, C.A.; Howard, K.E.; Wolf, J.C.; Smith, S.A.; Kennedy-Stoskopf, S. Transforming growth factor-b response to mycobacterial infection in striped bass Morone saxatilis and hybrid tilapia Oreochromis spp. Vet. Immunol. Immunopathol. 2003, 95, 155–163. [Google Scholar] [CrossRef] [PubMed]
- Pfaffl, M.W. A New Mathematical Model for Relative Quantification in Real-Time RT-PCR. Nucleic Acids Res. 2001, 29, e45. [Google Scholar] [CrossRef]
- Schmittgen, T.D.; Livak, K.J. Analyzing Real-Time PCR Data by the Comparative C(T) Method. Nat. Protoc. 2008, 3, 1101–1108. [Google Scholar] [CrossRef]
- Ruangpan, L.; Kitao, T.; Yoshida, T. Protective Efficacy of Aeromonas hydrophila Vaccines in Nile Tilapia. Vet. Immunol. Immunopathol. 1986, 12, 345–350. [Google Scholar] [CrossRef]
- Joseph, S.W.; Carnahan, A.; Fanning, G.R. Aeromonas jandaei (Formerly Genospecies DNA Group 9 A. sobria), a New Sucrose-Negative Species Isolated from Clinical Specimens. J. Clin. Microbiol. 1991, 29, 560–564. [Google Scholar] [CrossRef]
- Hickman-Brenner, F.W.; MacDonald, K.L.; Steigerwalt, A.G.; Fanning, G.R.; Brenner, D.J.; Farmer, J.J. Aeromonas veronii, a New Ornithine Decarboxylase-Positive Species That May Cause Diarrhea. J. Clin. Microbiol. 1987, 25, 900–906. [Google Scholar] [CrossRef]
- Paniagua, C.; Rivero, O.; Anguita, J.; Naharro, G. Pathogenicity Factors and Virulence for Rainbow Trout (Salmo gairdneri) of Motile Aeromonas Spp. Isolated from a River. J. Clin. Microbiol. 1990, 28, 350–355. [Google Scholar] [CrossRef] [PubMed]
- Abbott, S.L.; Cheung, W.K.W.; Janda, J.M. The Genus Aeromonas: Biochemical Characteristics, Atypical Reactions, and Phenotypic Identification Schemes. J. Clin. Microbiol. 2003, 41, 2348–2357. [Google Scholar] [CrossRef] [PubMed]
- Mittal, K.R.; Lalonde, G.; Leblanc, D.; Olivier, G.; Lallier, R. Aeromonas hydrophila in Rainbow Trout: Relation between Virulence and Surface Characteristics. Can. J. Microbiol. 1980, 26, 1501–1503. [Google Scholar] [CrossRef] [PubMed]
- Janda, J.M.; Oshiro, L.S.; Abbott, S.L.; Duffey, P.S. Virulence Markers of Mesophilic Aeromonads: Association of the Autoagglutination Phenomenon with Mouse Pathogenicity and the Presence of a Peripheral Cell-Associated Layer. Infect. Immun. 1987, 55, 3070–3077. [Google Scholar] [CrossRef] [PubMed]
- Dooley, J.S.; Trust, T.J. Surface Protein Composition of Aeromonas hydrophila Strains Virulent for Fish: Identification of a Surface Array Protein. J. Bacteriol. 1988, 170, 499–506. [Google Scholar] [CrossRef] [PubMed]
- Santos, Y.; Toranzo, A.E.; Barja, J.L.; Nieto, T.P.; Villa, T.G. Virulence Properties and Enterotoxin Production of Aeromonas Strains Isolated from Fish. Infect. Immun. 1988, 56, 3285–3293. [Google Scholar] [CrossRef] [PubMed]
- Youssef, H.A.; Ayoub, H.F.; Soror, E.I.; Matter, A.F. Virulence Genes Contributing to Aeromonas veronii Pathogenicity in Nile Tilapia (Oreochromis niloticus): Approaching the Development of Live and Inactivated Vaccines. Aquac. Int. 2023, 31, 1253–1267. [Google Scholar] [CrossRef] [PubMed]
- Rasmussen-Ivey, C.R.; Figueras, M.J.; McGarey, D.; Liles, M.R. Virulence Factors of Aeromonas hydrophila: In the Wake of Reclassification. Front. Microbiol. 2016, 7, 1337. [Google Scholar] [CrossRef]
- Angelidis, P.; Karagiannis, D.; Crump, E.M. Efficacy of a Listonella anguillarum (Syn. Vibrio anguillarum) Vaccine for Juvenile Sea Bass Dicentrarchus labrax. Dis. Aquat. Organ. 2006, 71, 19–24. [Google Scholar] [CrossRef]

| Replicate | Fish Group | No. Fish Dead/Examined | Mortality (%) | x2-Test | p-Value | Relative Percent Survival (RPS) | No. of Fish (+) Bacterial Re-Isolation/Examined | |
|---|---|---|---|---|---|---|---|---|
| Dead Fish | Survivor | |||||||
| 1 | Carrier | 9/20 | 45 | 3.137 | 0.077 ns | 40 | 9/9 | 4/11 |
| Vaccine | 5/20 | 25 | 8.100 | 0.004 ** | 67 | 5/5 | 1/15 | |
| Control (challenged) | 15/20 | 75 | 0 | 15/15 | 2/5 | |||
| Control (NSS-mock challenged) | 0/20 | 0 | 100 | - | 0/20 | |||
| 2 | Carrier | 8/20 | 40 | 3.683 | 0.055 ns | 47 | 8/8 | 1/12 |
| Vaccine | 7/20 | 35 | 4.949 | 0.026 * | 53 | 7/7 | 0/13 | |
| Control (challenged) | 15/20 | 75 | 0 | 15/15 | 0/5 | |||
| Control (NSS-mock challenged) | 0/20 | 0 | 100 | - | 0/20 | |||
Disclaimer/Publisher’s Note: The statements, opinions and data contained in all publications are solely those of the individual author(s) and contributor(s) and not of MDPI and/or the editor(s). MDPI and/or the editor(s) disclaim responsibility for any injury to people or property resulting from any ideas, methods, instructions or products referred to in the content. |
© 2024 by the authors. Licensee MDPI, Basel, Switzerland. This article is an open access article distributed under the terms and conditions of the Creative Commons Attribution (CC BY) license (https://creativecommons.org/licenses/by/4.0/).
Share and Cite
Argayosa, A.M.; Santos, M.N.M.; Argayosa, V.B.; Pakingking, R.V., Jr.; Buhian, W.; Salvador, M.L.; Teh, R.E. Pathogenicity of Aeromonas veronii from Nile Tilapia (Oreochromis niloticus) and Efficacy of Fish Oral Vaccine against Motile Aeromonad Septicemia in Tank Trials. Aquac. J. 2024, 4, 163-179. https://doi.org/10.3390/aquacj4030012
Argayosa AM, Santos MNM, Argayosa VB, Pakingking RV Jr., Buhian W, Salvador ML, Teh RE. Pathogenicity of Aeromonas veronii from Nile Tilapia (Oreochromis niloticus) and Efficacy of Fish Oral Vaccine against Motile Aeromonad Septicemia in Tank Trials. Aquaculture Journal. 2024; 4(3):163-179. https://doi.org/10.3390/aquacj4030012
Chicago/Turabian StyleArgayosa, Anacleto M., Mary Nia M. Santos, Vina B. Argayosa, Rolando V. Pakingking, Jr., William Buhian, Mizpah L. Salvador, and Rosaneth E. Teh. 2024. "Pathogenicity of Aeromonas veronii from Nile Tilapia (Oreochromis niloticus) and Efficacy of Fish Oral Vaccine against Motile Aeromonad Septicemia in Tank Trials" Aquaculture Journal 4, no. 3: 163-179. https://doi.org/10.3390/aquacj4030012
APA StyleArgayosa, A. M., Santos, M. N. M., Argayosa, V. B., Pakingking, R. V., Jr., Buhian, W., Salvador, M. L., & Teh, R. E. (2024). Pathogenicity of Aeromonas veronii from Nile Tilapia (Oreochromis niloticus) and Efficacy of Fish Oral Vaccine against Motile Aeromonad Septicemia in Tank Trials. Aquaculture Journal, 4(3), 163-179. https://doi.org/10.3390/aquacj4030012

